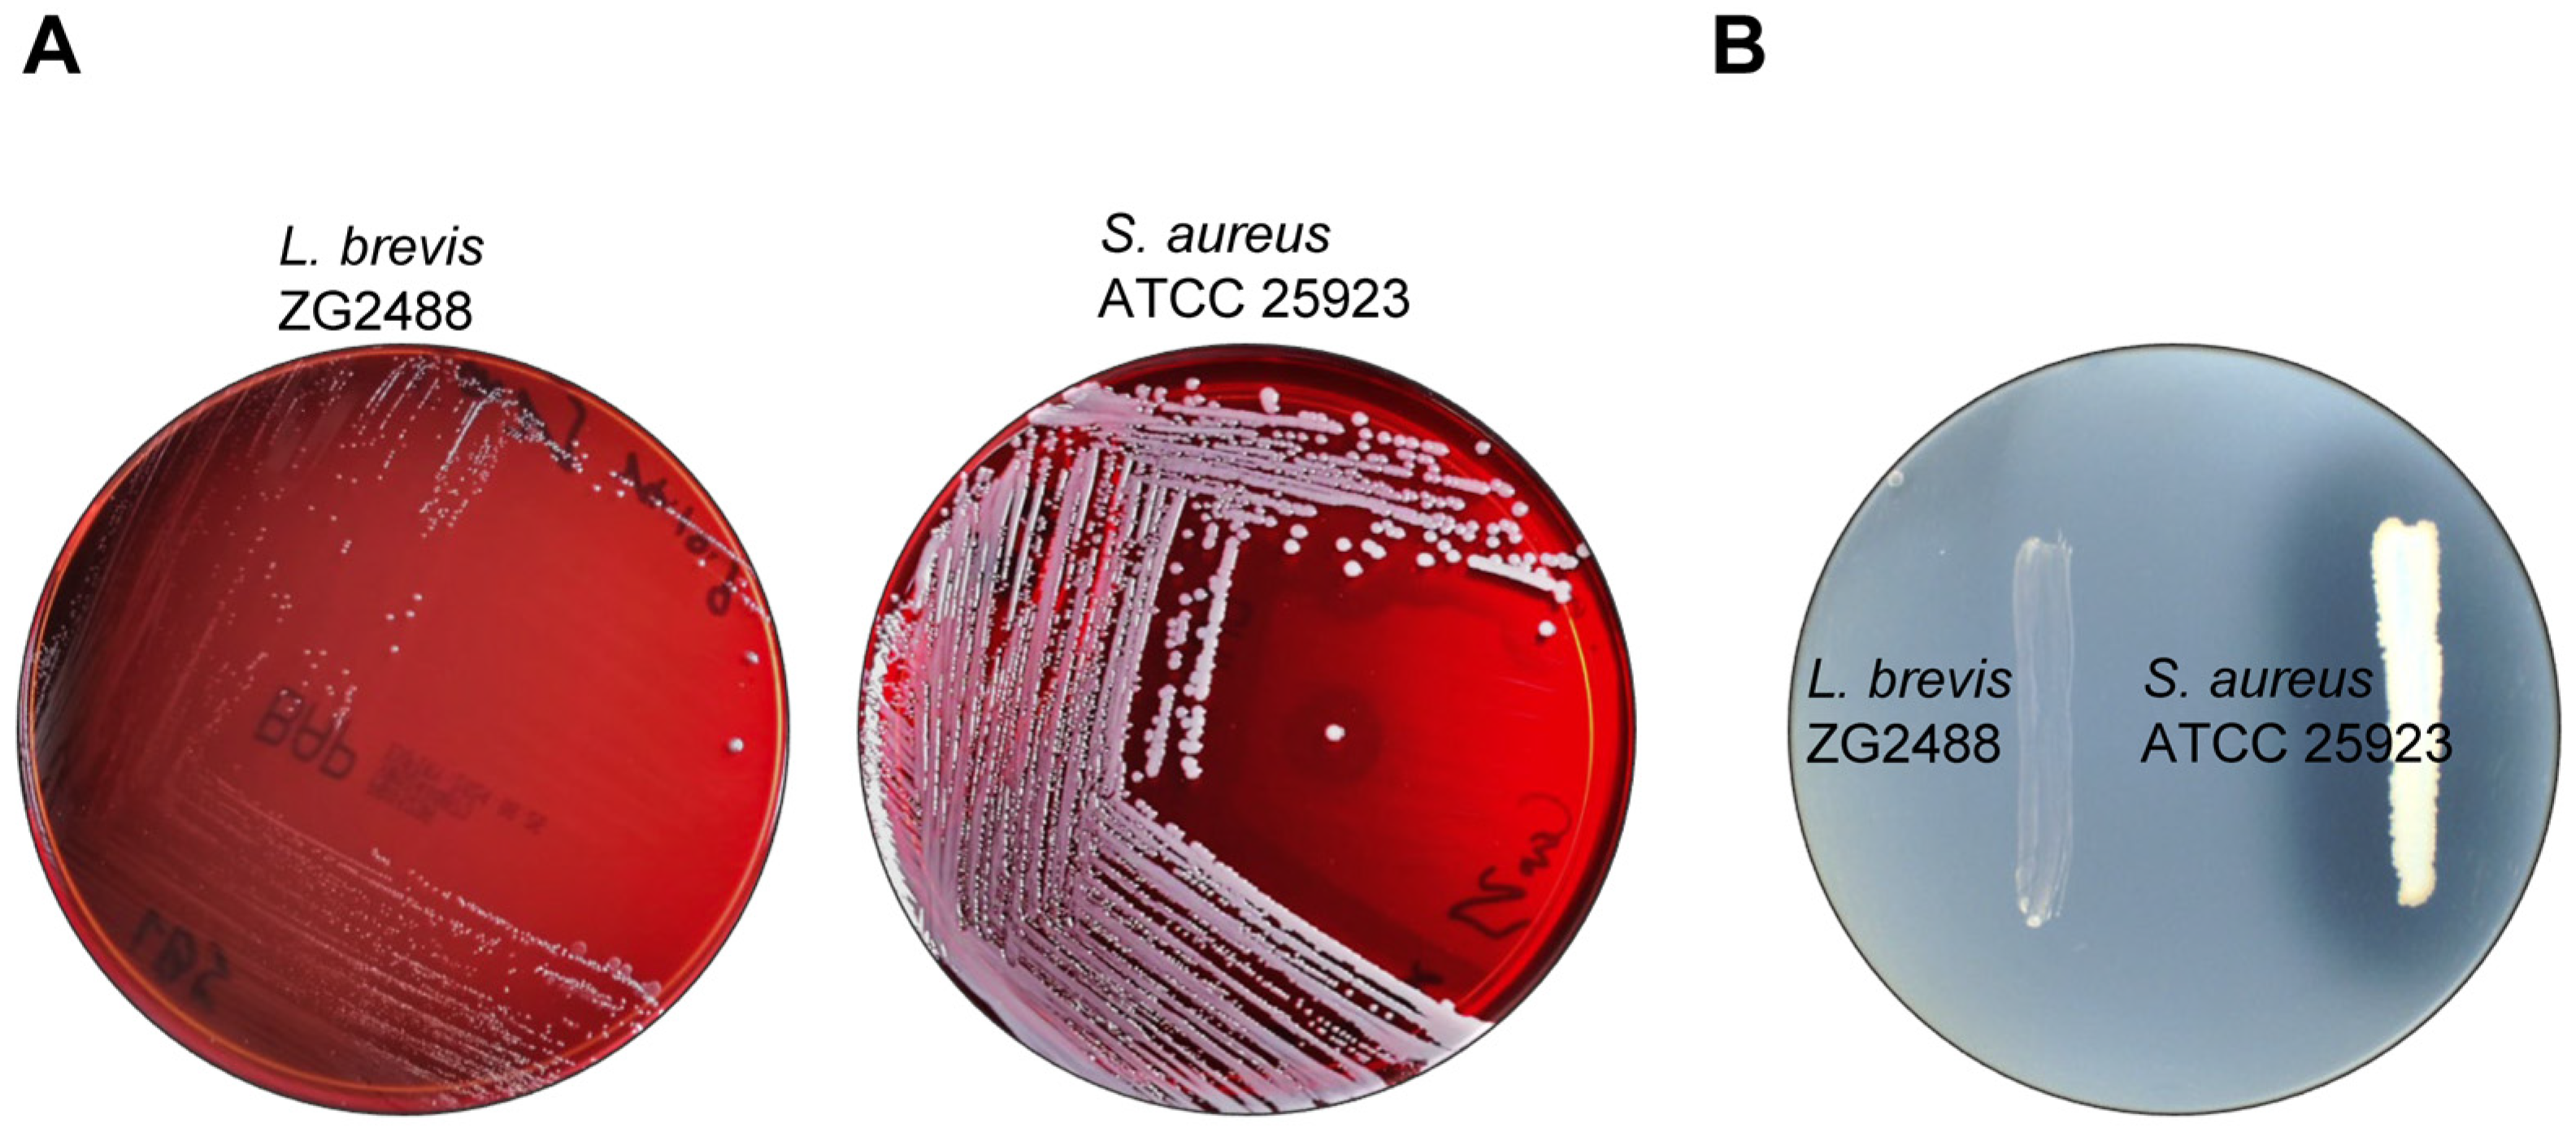
Fermentation 11 00287 g003

The Probiotic Potential, Safety, and Immunomodulatory Properties of Levilactobacillus brevis ZG2488: A Novel Strain Isolated from Healthy Human Feces
Abstract
1. Introduction
2. Materials and Methods
2.1. Isolation and Identification of L. brevis ZG2488
2.2. Strains and Growth Conditions
2.3. Cell Culture
2.4. Tolerance to Artificial Gastric Juice and Bile Salts
2.5. Cell Surface Hydrophobicity
2.6. Assays for Auto-Aggregation and Co-Aggregation
2.7. Adhesion Ability
2.8. Antimicrobial Activities
2.9. Hemolytic Activity
2.10. Deoxyribonuclease (DNase) Assay
2.11. Antibiotic Susceptibility Evaluation
2.12. Measurement of Cell Viability
2.13. Measurement of Nitric Oxide
2.14. Quantitative Real-Time Polymerase Chain Reaction (qRT-PCR)
2.15. Data Analysis
3. Results
3.1. Identification of L. brevis ZG2488
3.2. L. brevis ZG2488 Characters with Potential Probiotic Properties
3.3. In Vitro Safety Evaluation of L. brevis ZG2488
3.4. Immune-Stimulating Effect of L. brevis ZG2488 on RAW 264.7 Cells
3.5. Overexpression of Proinflammatory Gene for Immune Stimulation by L. brevis ZG2488 in RAW 264.7 Cells
4. Discussion
5. Conclusions
Author Contributions
Funding
Institutional Review Board Statement
Informed Consent Statement
Data Availability Statement
Acknowledgments
Conflicts of Interest
References
- Chandrasekaran, P.; Weiskirchen, S.; Weiskirchen, R. Effects of Probiotics on Gut Microbiota: An Overview. Int. J. Mol. Sci. 2024, 25, 6022. [Google Scholar] [CrossRef] [PubMed]
- Quigley, E.M.M.; Shanahan, F. Probiotics in Health Care: A Critical Appraisal. Annu. Rev. Med. 2025, 76, 129–141. [Google Scholar] [CrossRef] [PubMed]
- Wang, X.; Zhang, P.; Zhang, X. Probiotics Regulate Gut Microbiota: An Effective Method to Improve Immunity. Molecules 2021, 26, 6076. [Google Scholar] [CrossRef] [PubMed]
- Song, J.A.; Kim, H.J.; Hong, S.K.; Lee, D.H.; Lee, S.W.; Song, C.S.; Kim, K.T.; Choi, I.S.; Lee, J.B.; Park, S.Y. Oral intake of Lactobacillus rhamnosus M21 enhances the survival rate of mice lethally infected with influenza virus. J. Microbiol. Immunol. Infect. 2016, 49, 16–23. [Google Scholar] [CrossRef]
- He, G.; Long, H.; He, J.; Zhu, C. The Immunomodulatory Effects and Applications of Probiotic Lactiplantibacillus plantarum in Vaccine Development. Probiotics Antimicrob. Proteins 2024, 16, 2229–2250. [Google Scholar] [CrossRef]
- Wang, R.; Yu, Y.F.; Yu, W.R.; Sun, S.Y.; Lei, Y.M.; Li, Y.X.; Lu, C.X.; Zhai, J.N.; Bai, F.R.; Ren, F.; et al. Roles of Probiotics, Prebiotics, and Postbiotics in B-Cell-Mediated Immune Regulation. J. Nutr. 2025, 155, 37–51. [Google Scholar] [CrossRef]
- Mazziotta, C.; Tognon, M.; Martini, F.; Torreggiani, E.; Rotondo, J.C. Probiotics Mechanism of Action on Immune Cells and Beneficial Effects on Human Health. Cells 2023, 12, 184. [Google Scholar] [CrossRef]
- Ashraf, R.; Shah, N.P. Immune system stimulation by probiotic microorganisms. Crit. Rev. Food Sci. Nutr. 2014, 54, 938–956. [Google Scholar] [CrossRef]
- Noh, H.J.; Park, J.M.; Kwon, Y.J.; Kim, K.; Park, S.Y.; Kim, I.; Lim, J.H.; Kim, B.K.; Kim, B.Y. Immunostimulatory Effect of Heat-Killed Probiotics on RAW264.7 Macrophages. J. Microbiol. Biotechnol. 2022, 32, 638–644. [Google Scholar] [CrossRef]
- Ali, M.S.; Lee, E.B.; Quah, Y.; Sayem, S.A.J.; Abbas, M.A.; Suk, K.; Lee, S.J.; Park, S.C. Modulating effects of heat-killed and live Limosilactobacillus reuteri PSC102 on the immune response and gut microbiota of cyclophosphamide-treated rats. Vet. Q. 2024, 44, 1–18. [Google Scholar] [CrossRef]
- Park, H.E.; Do, K.H.; Lee, W.K. The immune-modulating effects of viable Weissella cibaria JW15 on RAW 264.7 macrophage cells. J. Biomed. Res. 2019, 34, 36–43. [Google Scholar] [CrossRef] [PubMed]
- You, Y.; Kim, S.H.; Kim, C.H.; Kim, I.H.; Shin, Y.; Kim, T.R.; Sohn, M.; Park, J. Immune-Stimulating Potential of Lacticaseibacillus rhamnosus LM1019 in RAW 264.7 Cells and Immunosuppressed Mice Induced by Cyclophosphamide. Microorganisms 2023, 11, 2312. [Google Scholar] [CrossRef] [PubMed]
- Fang, F.; Xu, J.; Li, Q.; Xia, X.; Du, G. Characterization of a Lactobacillus brevis strain with potential oral probiotic properties. BMC Microbiol. 2018, 18, 221. [Google Scholar] [CrossRef] [PubMed]
- Hyun, J.H.; Yu, H.S.; Woo, I.K.; Lee, G.W.; Lee, N.K.; Paik, H.D. Anti-inflammatory activities of Levilactobacillus brevis KU15147 in RAW 264.7 cells stimulated with lipopolysaccharide on attenuating NF-kappaB, AP-1, and MAPK signaling pathways. Food Sci. Biotechnol. 2023, 32, 2105–2115. [Google Scholar] [CrossRef]
- Han, X.; Ding, S.; Ma, Y.; Fang, J.; Jiang, H.; Li, Y.; Liu, G. Lactobacillus plantarum and Lactobacillus brevis Alleviate Intestinal Inflammation and Microbial Disorder Induced by ETEC in a Murine Model. Oxid. Med. Cell Longev. 2021, 2021, 6867962. [Google Scholar] [CrossRef]
- Jang, H.J.; Lee, N.K.; Paik, H.D. Probiotic characterization of Lactobacillus brevis KU15153 showing antimicrobial and antioxidant effect isolated from kimchi. Food Sci. Biotechnol. 2019, 28, 1521–1528. [Google Scholar] [CrossRef]
- Jeong, M.; Kim, J.H.; Lee, J.S.; Kang, S.D.; Shim, S.; Jung, M.Y.; Yang, H.; Byun, S.; Lee, K.W. Heat-Killed Lactobacillus brevis Enhances Phagocytic Activity and Generates Immune-Stimulatory Effects through Activating the TAK1 Pathway. J. Microbiol. Biotechnol. 2020, 30, 1395–1403. [Google Scholar] [CrossRef]
- Kim, K.T.; Yang, S.J.; Paik, H.D. Probiotic properties of novel probiotic Levilactobacillus brevis KU15147 isolated from radish kimchi and its antioxidant and immune-enhancing activities. Food Sci. Biotechnol. 2021, 30, 257–265. [Google Scholar] [CrossRef]
- Verdenelli, M.C.; Ghelfi, F.; Silvi, S.; Orpianesi, C.; Cecchini, C.; Cresci, A. Probiotic properties of Lactobacillus rhamnosus and Lactobacillus paracasei isolated from human faeces. Eur. J. Nutr. 2009, 48, 355–363. [Google Scholar] [CrossRef]
- Kunduhoglu, B.; Hacioglu, S. Probiotic Potential and Gluten Hydrolysis Activity of Lactobacillus brevis KT16-2. Probiotics Antimicrob. Proteins 2021, 13, 720–733. [Google Scholar] [CrossRef]
- Lo Presti, A.; Del Chierico, F.; Altomare, A.; Zorzi, F.; Monteleone, G.; Putignani, L.; Angeletti, S.; Cicala, M.; Guarino, M.P.L.; Ciccozzi, M. Phylogenetic analysis of Prevotella copri from fecal and mucosal microbiota of IBS and IBD patients. Therap. Adv. Gastroenterol. 2023, 16, 1–10. [Google Scholar] [CrossRef] [PubMed]
- Zibaei-Rad, A.; Rahmati-Joneidabad, M.; Behbahani, B.A.; Taki, M. Assessing the protection mechanisms on Enterobacter aerogenes ATCC 13048 by potentially probiotic strain Lacticaseibacillus casei XN18: An experimental and modeling study. Microb. Pathog. 2023, 181, 106177. [Google Scholar] [CrossRef]
- CLSI. CLSI M100. Performance Standards for Antimicrobial Susceptibility Testing; Clinical and Laboratory Standards Institute: Pittsburgh, PA, USA, 2024. [Google Scholar]
- Korhonen, R.; Lahti, A.; Kankaanranta, H.; Moilanen, E. Nitric oxide production and signaling in inflammation. Curr. Drug Targets Inflamm. Allergy 2005, 4, 471–479. [Google Scholar] [CrossRef]
- Hacıoglu, S.; Kunduhoglu, B. Probiotic Characteristics of Lactobacillus brevis KT38-3 Isolated from an Artisanal Tulum Cheese. Food Sci. Anim. Resour. 2021, 41, 967–982. [Google Scholar] [CrossRef]
- Somashekaraiah, R.; Mottawea, W.; Gunduraj, A.; Joshi, U.; Hammami, R.; Sreenivasa, M.Y. Probiotic and Antifungal Attributes of Levilactobacillus brevis MYSN105, Isolated from an Indian Traditional Fermented Food Pozha. Front. Microbiol. 2021, 12, 696267. [Google Scholar] [CrossRef]
- Monteagudo-Mera, A.; Rastall, R.A.; Gibson, G.R.; Charalampopoulos, D.; Chatzifragkou, A. Adhesion mechanisms mediated by probiotics and prebiotics and their potential impact on human health. Appl. Microbiol. Biotechnol. 2019, 103, 6463–6472. [Google Scholar] [CrossRef]
- Sophatha, B.; Piwat, S.; Teanpaisan, R. Adhesion, anti-adhesion and aggregation properties relating to surface charges of selected Lactobacillus strains: Study in Caco-2 and H357 cells. Arch. Microbiol. 2020, 202, 1349–1357. [Google Scholar] [CrossRef]
- Sambuy, Y.; De Angelis, I.; Ranaldi, G.; Scarino, M.L.; Stammati, A.; Zucco, F. The Caco-2 cell line as a model of the intestinal barrier: Influence of cell and culture-related factors on Caco-2 cell functional characteristics. Cell Biol. Toxicol. 2005, 21, 1–26. [Google Scholar] [CrossRef]
- Coconnier, M.H.; Klaenhammer, T.R.; Kerneis, S.; Bernet, M.F.; Servin, A.L. Protein-mediated adhesion of Lactobacillus acidophilus BG2FO4 on human enterocyte and mucus-secreting cell lines in culture. Appl. Environ. Microbiol. 1992, 58, 2034–2039. [Google Scholar] [CrossRef]
- Kim, W.J.; Hyun, J.H.; Lee, N.K.; Paik, H.D. Protective Effects of a Novel Lactobacillus brevis Strain with Probiotic Characteristics against Staphylococcus aureus Lipoteichoic Acid-Induced Intestinal Inflammatory Response. J. Microbiol. Biotechnol. 2022, 32, 205–211. [Google Scholar] [CrossRef]
- Hojjati, M.; Behabahani, B.A.; Falah, F. Aggregation, adherence, anti-adhesion and antagonistic activity properties relating to surface charge of probiotic Lactobacillus brevis gp104 against Staphylococcus aureus. Microb. Pathog. 2020, 147, 104420. [Google Scholar] [CrossRef] [PubMed]
- Alizadeh Behbahani, B.; Jooyandeh, H.; Hojjati, M.; Ghodsi Sheikhjan, M. Evaluation of probiotic, safety, and anti-pathogenic properties of Levilactobacillus brevis HL6, and its potential application as bio-preservatives in peach juice. Lwt 2024, 191, 115601. [Google Scholar] [CrossRef]
- Nunziata, L.; Brasca, M.; Morandi, S.; Silvetti, T. Antibiotic resistance in wild and commercial non-enterococcal Lactic Acid Bacteria and Bifidobacteria strains of dairy origin: An update. Food Microbiol. 2022, 104, 103999. [Google Scholar] [CrossRef] [PubMed]
- Sornsenee, P.; Singkhamanan, K.; Sangkhathat, S.; Saengsuwan, P.; Romyasamit, C. Probiotic Properties of Lactobacillus Species Isolated from Fermented Palm Sap in Thailand. Probiotics Antimicrob. Proteins 2021, 13, 957–969. [Google Scholar] [CrossRef]
- Lee, S.M.; Choi, W.; Shin, W.R.; Kim, Y.H.; Min, J. Enhanced immune response by vacuoles isolated from Saccharomyces cerevisiae in RAW 264.7 macrophages. Biosci. Rep. 2021, 41, BSR20211158. [Google Scholar] [CrossRef]
- Jung, J.Y.; Shin, J.S.; Lee, S.G.; Rhee, Y.K.; Cho, C.W.; Hong, H.D.; Lee, K.T. Lactobacillus sakei K040706 evokes immunostimulatory effects on macrophages through TLR 2-mediated activation. Int. Immunopharmacol. 2015, 28, 88–96. [Google Scholar] [CrossRef]

| Indicator Strain | Inhibition Zone Diameter (mm) of L. brevis ZG2488 |
|---|---|
| Staphylococcus aureus ATCC 25923 | 19.80 ± 1.21 |
| Salmonella typhimurium SL1344 | 15.50 ± 1.21 |
| Escherichia coli ATCC 43895 | 14.70 ± 0.85 |
| Listeria monocytogenes ATCC BAA-679 | 13.93 ± 0.76 |
| Klebsiella pneumoniae NK04152 | 13.70 ± 1.61 |
| Antibiotic | Result | Inhibition Zone Diameter (mm) |
|---|---|---|
| Imipenem (10 µg/disk) | S | 44.11 ± 1.39 |
| Erythromycin (15 µg/disk) | S | 32.86 ± 0.98 |
| Chloramphenicol (30 µg/disk) | S | 32.37 ± 1.72 |
| Amoxicillin/clavulanic acid (30 µg/disk) | S | 28.17 ± 0.71 |
| Minocycline (30 µg/disk) | S | 27.01 ± 0.31 |
| Clindamycin (10 µg/disk) | S | 26.90 ± 1.52 |
| Azithromycin (15 µg/disk) | S | 26.68 ± 0.90 |
| Trimethoprim (5 µg/disk) | S | 24.50 ± 0.62 |
| Netilmicin (30 µg/disk) | S | 22.87 ± 0.29 |
| Tetracycline (30 µg/disk) | S | 19.65 ± 1.15 |
| Gentamicin (10 µg/disk) | I | 16.88 ± 0.20 |
| Kanamycin (30 µg/disk) | R | 8.64 ± 0.20 |
| Penicillin G (10 µg/disk) | R | 8.57 ± 0.25 |
| Streptomycin (10 µg/disk) | R | 6.21 ± 0.09 |
| Vancomycin (30 µg/disk) | R | 6.16 ± 0.13 |
Disclaimer/Publisher’s Note: The statements, opinions and data contained in all publications are solely those of the individual author(s) and contributor(s) and not of MDPI and/or the editor(s). MDPI and/or the editor(s) disclaim responsibility for any injury to people or property resulting from any ideas, methods, instructions or products referred to in the content. |
© 2025 by the authors. Licensee MDPI, Basel, Switzerland. This article is an open access article distributed under the terms and conditions of the Creative Commons Attribution (CC BY) license (https://creativecommons.org/licenses/by/4.0/).
Share and Cite
Cao, Z.; Chen, M.; Chen, Y.; Sun, H. The Probiotic Potential, Safety, and Immunomodulatory Properties of Levilactobacillus brevis ZG2488: A Novel Strain Isolated from Healthy Human Feces. Fermentation 2025, 11, 287. https://doi.org/10.3390/fermentation11050287
Cao Z, Chen M, Chen Y, Sun H. The Probiotic Potential, Safety, and Immunomodulatory Properties of Levilactobacillus brevis ZG2488: A Novel Strain Isolated from Healthy Human Feces. Fermentation. 2025; 11(5):287. https://doi.org/10.3390/fermentation11050287
Chicago/Turabian StyleCao, Zhijie, Mengshan Chen, Yulu Chen, and Hui Sun. 2025. "The Probiotic Potential, Safety, and Immunomodulatory Properties of Levilactobacillus brevis ZG2488: A Novel Strain Isolated from Healthy Human Feces" Fermentation 11, no. 5: 287. https://doi.org/10.3390/fermentation11050287
APA StyleCao, Z., Chen, M., Chen, Y., & Sun, H. (2025). The Probiotic Potential, Safety, and Immunomodulatory Properties of Levilactobacillus brevis ZG2488: A Novel Strain Isolated from Healthy Human Feces. Fermentation, 11(5), 287. https://doi.org/10.3390/fermentation11050287

